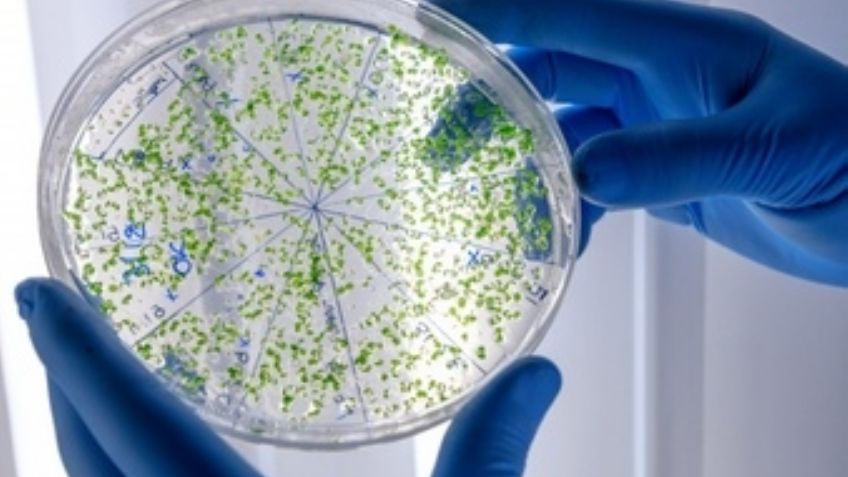
¡Alerta! El cambio climático ayuda a las bacterias a evolucionar rápidamente

California, Estados Unidos.- No es ningún secreto que el cambio climático afecta la salud de las personas, pero no se sabia en que medida afecta al aumento de enfermedades, hasta ahora, gracias a una investigación de la Universidad de California.
De acuerdo con el estudio publicado en la revista Proceedings of the National Academy of Sciences, el cambio climático ayuda a las bacterias a evolucionar con una velocidad realmente alarmante.
Hasta el momento se conoce que los microbios del suelo, específicamente, pueden reproducirse en tan solo unas horas, por lo que es posible que se desarrolle una mutación genética en un periodo de tiempo muy corto, sin embargo, esos hallazgos se hicieron a través de experimentos controlados.
Por lo cual no está claro hasta qué punto la evolución de estos organismos se puede ver afectada por las tasas actuales del cambio climático.
El estudio muestra que podemos observar una rápida evolución en los microbios del suelo, y este es un logro emocionante. Nuestro próximo objetivo es comprender la importancia de la adaptación evolutiva de los ecosistemas del suelo bajo el cambio climático futuro'', señalan los expertos.
Es posible estas bacterias puedan producir algunas enfermedades peligrosas para el ser humano, y su rápida modificación evitaría encontrar soluciones efectivas pronto, según información de a investigación, por lo que los científicos aseguran que se necesita comprender aun más como el cambio climático afecta la composición de los microbios.
Fuente: Phys.org